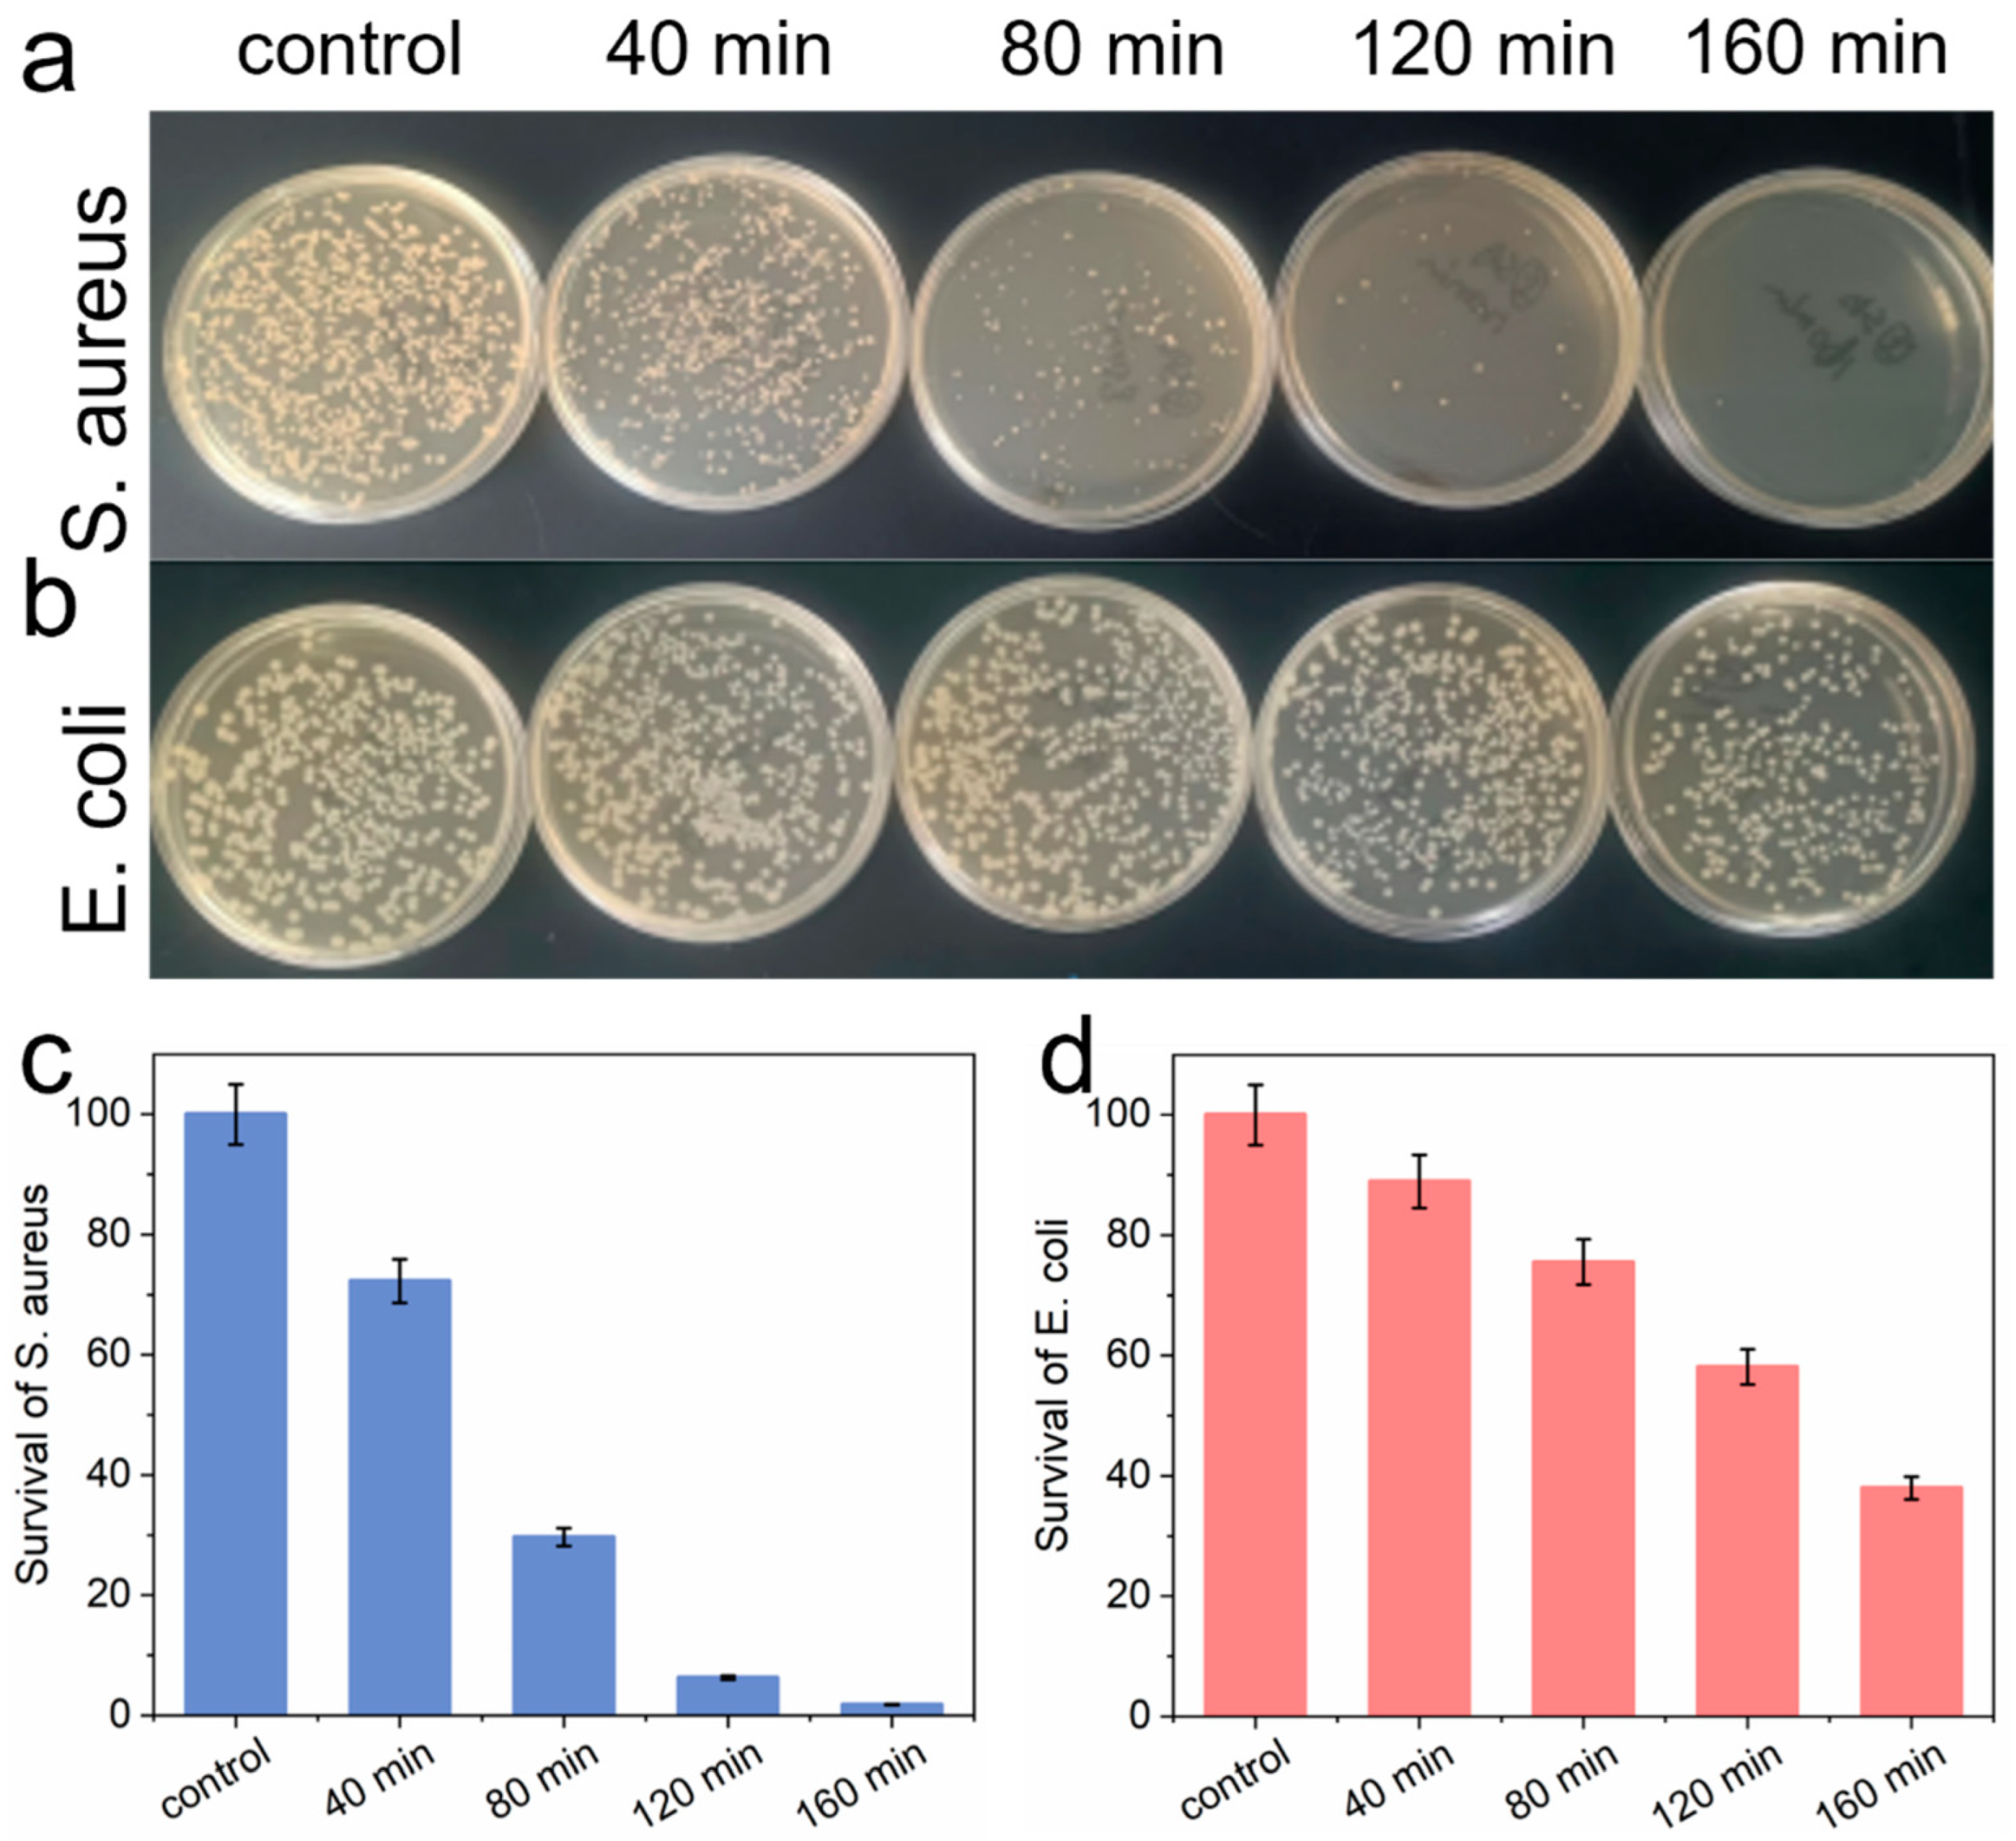
Nanomaterials 14 01369 g004

The Construction of Iodine-Doped Carbon Nitride as a Metal-Free Nanozyme for Antibacterial and Water Treatment
Abstract
1. Introduction
2. Experimental Methods
2.1. Catalyst Preparation and Characterization
2.2. Antibacterial Performance
2.3. Experimental Procedures
3. Results and Discussion
3.1. Characterization of I-CN
3.2. Photocatalytic Property Characterization and Mechanism Analysis
3.3. Antibacterial Ability
3.4. Catalytic Performance of I-CN
4. Conclusions
Supplementary Materials
Author Contributions
Funding
Data Availability Statement
Conflicts of Interest
References
- Yang, B.; Pang, X.; Li, Z.; Chen, Z.; Wang, Y. Immunomodulation in the Treatment of Periodontitis: Progress and Perspectives. Front. Immunol. 2021, 12, 781378. [Google Scholar] [CrossRef]
- Offenbacher, S.; Jiao, Y.; Kim, S.J.; Marchesan, J.; Moss, K.L.; Jing, L.; Divaris, K.; Bencharit, S.; Agler, C.S.; Morelli, T.; et al. GWAS for Interleukin-1β levels in gingival crevicular fluid identifies IL37 variants in periodontal inflammation. Nat. Commun. 2018, 9, 3686. [Google Scholar] [CrossRef] [PubMed]
- Kong, Q.; Qi, M.; Li, W.; Shi, Y.; Su, J.; Xiao, S.; Sun, J.; Bai, X.; Dong, B.; Wang, L. A Novel Z-Scheme Heterostructured Bi2S3/Cu-TCPP Nanocomposite with Synergistically Enhanced Therapeutics against Bacterial Biofilm Infections in Periodontitis. Small 2023, 19, 2302547. [Google Scholar] [CrossRef]
- Yu, Y.; Cheng, Y.; Tan, L.; Liu, X.; Li, Z.; Zheng, Y.; Wu, T.; Liang, Y.; Cui, Z.; Zhu, S.; et al. Theory-screened MOF-based single-atom catalysts for facile and effective therapy of biofilm-induced periodontitis. Chem. Eng. J. 2022, 431, 133279. [Google Scholar] [CrossRef]
- Manoharan, R.K.; Ishaque, F.; Ahn, Y.-H. Fate of antibiotic resistant genes in wastewater environments and treatment strategies—A review. Chemosphere 2022, 298, 134671. [Google Scholar] [CrossRef] [PubMed]
- Liu, J.; Wan, J.; Liu, L.; Yang, W.; Low, J.; Gao, X.; Fu, F. Synergistic effect of oxygen defect and doping engineering on S-scheme O-ZnIn2S4/TiO2-x heterojunction for effective photocatalytic hydrogen production by water reduction coupled with oxidative dehydrogenation. Chem. Eng. J. 2022, 430, 133125. [Google Scholar] [CrossRef]
- Li, H.; Ji, H.; Liu, J.; Liu, W.; Li, F.; Shen, Z. Interfacial modulation of ZnIn2S4 with high active Zr-S4 sites for boosting photocatalytic activation of oxygen and degradation of emerging contaminant. Appl. Catal. B Environ. 2023, 328, 122481. [Google Scholar] [CrossRef]
- Chi, X.; Lan, Z.-A.; Chen, Q.; Zhang, X.; Chen, X.; Zhang, G.; Wang, X. Electronic Transmission Channels Promoting Charge Separation of Conjugated Polymers for Photocatalytic CO2 Reduction with Controllable Selectivity. Angew. Chem. Int. Ed. 2023, 62, e202303785. [Google Scholar] [CrossRef]
- Yu, P.; Zhou, X.; Li, Z.; Yan, Y. Inactivation and change of tetracycline-resistant Escherichia coli in secondary effluent by visible light-driven photocatalytic process using Ag/AgBr/g-C3N4. Sci. Total Environ. 2020, 705, 135639. [Google Scholar] [CrossRef]
- Wang, C.; Luo, Y.; Liu, X.; Cui, Z.; Zheng, Y.; Liang, Y.; Li, Z.; Zhu, S.; Lei, J.; Feng, X.; et al. The enhanced photocatalytic sterilization of MOF-Based nanohybrid for rapid and portable therapy of bacteria-infected open wounds. Bioact. Mater. 2022, 13, 200–211. [Google Scholar] [CrossRef]
- Miao, R.; Liu, H.; Lei, Q.; Zhong, L.; Zhang, L.; He, J.; Ma, Z.; Yao, Y. Single-organic component g-C3.6N4 achieves superior photoactivity antibacterial. Chem. Eng. J. 2022, 440, 135873. [Google Scholar] [CrossRef]
- Lv, M.; Wang, K.; Liang, X.; Chen, Y.; Tang, X.; Liu, R.; Chen, W. Principle of CoS2/ZnIn2S4 heterostructure effect and its mechanism of action in a visible light-catalyzed antibacterial process. J. Colloid Interface Sci. 2024, 653, 879–893. [Google Scholar] [CrossRef] [PubMed]
- Yang, J.; Xie, T.; Mei, Y.; Chen, J.; Sun, H.; Feng, S.; Zhang, Y.; Zhao, Y.; Wang, J.; Li, X.; et al. High-efficiency V-Mediated Bi2MoO6 photocatalyst for PMS activation: Modulation of energy band structure and enhancement of surface reaction. Appl. Catal. B Environ. 2023, 339, 123149. [Google Scholar] [CrossRef]
- Akbari, S.; Moussavi, G.; Decker, J.; Marin, M.L.; Bosca, F.; Giannakis, S. Superior visible light-mediated catalytic activity of a novel N-doped, Fe3O4-incorporating MgO nanosheet in presence of PMS: Imidacloprid degradation and implications on simultaneous bacterial inactivation. Appl. Catal. B Environ. 2022, 317, 121732. [Google Scholar] [CrossRef]
- Liu, H.; Cao, S.; Chen, L.; Zhao, K.; Wang, C.; Li, M.; Shen, S.; Wang, W.; Ge, L. Electron acceptor design for 2D/2D iodinene/carbon nitride heterojunction boosting charge transfer and CO2 photoreduction. Chem. Eng. J. 2022, 433, 133594. [Google Scholar] [CrossRef]
- Liu, X.; Chen, Y.; Yao, Y.; Bai, Q.; Wu, Z. Iodine-doped carbon fibers as an efficient metal-free catalyst to activate peroxymonosulfate for the removal of organic pollutants. Catal. Sci. Technol. 2018, 8, 5482–5489. [Google Scholar] [CrossRef]
- Ikeda, N.; Fujibayashi, S.; Yamaguchi, S.; Goto, K.; Otsuki, B.; Kawai, T.; Shimizu, T.; Okuzu, Y.; Masamoto, K.; Shimizu, Y.; et al. Bioactivity and antibacterial activity of iodine-containing calcium titanate against implant-associated infection. Biomater. Adv. 2022, 138, 212952. [Google Scholar] [CrossRef]
- Tanzer, J.M.; Slee, A.M.; Kamay, B.; Scheer, E.R. In vitro evaluation of three iodine-containing compounds as antiplaque agents. Antimicrob. Agents Chemother. 1977, 12, 107–113. [Google Scholar] [CrossRef][Green Version]
- Li, X.; Wu, X.; Yuan, T.; Zhu, J.; Yang, Y. Influence of the iodine content of nitrogen- and iodine-doped carbon dots as a peroxidase mimetic nanozyme exhibiting antifungal activity against C. albicans. Biochem. Eng. J. 2021, 175, 108139. [Google Scholar] [CrossRef]
- Li, X.; Xu, Y.; Ouyang, D.; Ye, K.; Chen, Y.; Li, Q.; Xia, Q.; Wu, X.; Yang, Y. Copper- and iodine-doped nanozymes with simulated enzyme activity and efficient antifungal activity against Candida albicans. Biochem. Eng. J. 2023, 191, 108791. [Google Scholar] [CrossRef]
- Óvári, L.; Farkas, A.P.; Palotás, K.; Vári, G.; Szenti, I.; Berkó, A.; Kiss, J.; Kónya, Z. Hexagonal boron nitride on metal surfaces as a support and template. Surf. Sci. Rep. 2024, 100637. [Google Scholar] [CrossRef]
- Yan, M.; Li, Y.; Xu, Q.; Wei, X.; Xiao, P.; Chen, F.; Yang, L.; Wu, X.-L. Enhanced electron-transfer for peroxymonosulfate activation by Ni single sites adjacent to Ni nanoparticles. J. Colloid Interface Sci. 2024, 654, 979–987. [Google Scholar] [CrossRef] [PubMed]
- Liu, S.; Liu, D.; Sun, Y.; Xiao, P.; Lin, H.; Chen, J.; Wu, X.-L.; Duan, X.; Wang, S. Enzyme-mimicking single-atom FeN4 sites for enhanced photo-Fenton-like reactions. Appl. Catal. B Environ. 2022, 310, 121327. [Google Scholar] [CrossRef]
- Silva, R.R.M.; Ruotolo, L.A.M.; Nogueira, F.G.E. Peroxymonosulfate activation by magnetic NiFe2O4/g-C3N4 for tetracycline hydrochloride degradation under visible light. Chem. Eng. J. 2023, 476, 146621. [Google Scholar] [CrossRef]
- Sun, K.; Wang, C.; Tebyetekerwa, M.; Zhao, X.S. Electrocapacitive desalination with nitrogen-doped hierarchically structured carbon prepared using a sustainable salt-template method. Chem. Eng. J. 2022, 446, 137211. [Google Scholar] [CrossRef]
- Han, H.; Meng, X. Hydrothermal preparation of C3N4 on carbonized wood for photothermal-photocatalytic water splitting to efficiently evolve hydrogen. J. Colloid Interface Sci. 2023, 650, 846–856. [Google Scholar] [CrossRef]
- Ruan, X.; Cui, X.; Jia, G.; Wu, J.; Zhao, J.; Singh, D.J.; Liu, Y.; Zhang, H.; Zhang, L.; Zheng, W. Intramolecular heterostructured carbon nitride with heptazine-triazine for enhanced photocatalytic hydrogen evolution. Chem. Eng. J. 2022, 428, 132579. [Google Scholar] [CrossRef]
- Xie, W.; Wang, S.; Lv, J.; You, Z.; Yu, W.; Liu, X.; Wang, M.-Y.; Ma, X. Bifunctional Y/g-C3N4 promoted cycloaddition of CO2 to epoxide: Halogen-free and acid-base synergistic catalysis. Chem. Eng. Sci. 2023, 281, 119206. [Google Scholar] [CrossRef]
- Wu, X.-L.; Liu, S.; Li, Y.; Yan, M.; Lin, H.; Chen, J.; Liu, S.; Wang, S.; Duan, X. Directional and Ultrafast Charge Transfer in Oxygen-Vacancy-Rich ZnO@Single-Atom Cobalt Core-Shell Junction for Photo-Fenton-Like Reaction. Angew. Chem. Int. Ed. 2023, 62, e202305639. [Google Scholar] [CrossRef]
- Zhang, Y.; Guo, Z.; Yu, M.; Xu, Z.; Liu, Y.; Li, F.; Wang, L. Preparation of enhanced AgI@MnO2 heterojunction photocatalysts for rapid sterilization under visible light. J. Alloys Compd. 2021, 887, 161431. [Google Scholar] [CrossRef]
- Veras, E.L.; Castro Dos Santos, N.; Souza, J.G.S.; Figueiredo, L.C.; Retamal-Valdes, B.; Barão, V.A.R.; Shibli, J.; Bertolini, M.; Faveri, M.; Teles, F.; et al. Newly identified pathogens in periodontitis: Evidence from an association and an elimination study. J. Oral Microbiol. 2023, 15, 2213111. [Google Scholar] [CrossRef]
- Shang, K.; Ai, S.; Ma, Q.; Tang, T.; Yin, H.; Han, H. Effective photocatalytic disinfection of E. coli and S. aureus using polythiophene/MnO2 nanocomposite photocatalyst under solar light irradiation. Desalination 2011, 278, 173–178. [Google Scholar] [CrossRef]
- Chen, Y.; Tang, X.; Gao, X.; Zhang, B.; Luo, Y.; Yao, X. Antimicrobial property and photocatalytic antibacterial mechanism of the TiO2-doped SiO2 hybrid materials under ultraviolet-light irradiation and visible-light irradiation. Ceram. Int. 2019, 45, 15505–15513. [Google Scholar] [CrossRef]

Disclaimer/Publisher’s Note: The statements, opinions and data contained in all publications are solely those of the individual author(s) and contributor(s) and not of MDPI and/or the editor(s). MDPI and/or the editor(s) disclaim responsibility for any injury to people or property resulting from any ideas, methods, instructions or products referred to in the content. |
© 2024 by the authors. Licensee MDPI, Basel, Switzerland. This article is an open access article distributed under the terms and conditions of the Creative Commons Attribution (CC BY) license (https://creativecommons.org/licenses/by/4.0/).
Share and Cite
Cai, X.; Xie, T.; Luo, L.; Li, X. The Construction of Iodine-Doped Carbon Nitride as a Metal-Free Nanozyme for Antibacterial and Water Treatment. Nanomaterials 2024, 14, 1369. https://doi.org/10.3390/nano14161369
Cai X, Xie T, Luo L, Li X. The Construction of Iodine-Doped Carbon Nitride as a Metal-Free Nanozyme for Antibacterial and Water Treatment. Nanomaterials. 2024; 14(16):1369. https://doi.org/10.3390/nano14161369
Chicago/Turabian StyleCai, Xinru, Tongtong Xie, Linshan Luo, and Xiting Li. 2024. "The Construction of Iodine-Doped Carbon Nitride as a Metal-Free Nanozyme for Antibacterial and Water Treatment" Nanomaterials 14, no. 16: 1369. https://doi.org/10.3390/nano14161369
APA StyleCai, X., Xie, T., Luo, L., & Li, X. (2024). The Construction of Iodine-Doped Carbon Nitride as a Metal-Free Nanozyme for Antibacterial and Water Treatment. Nanomaterials, 14(16), 1369. https://doi.org/10.3390/nano14161369

